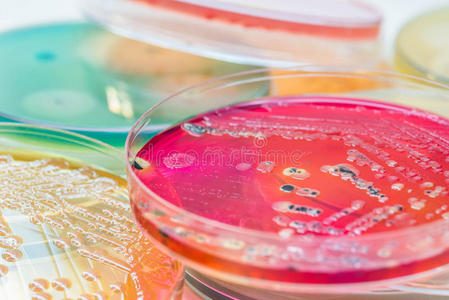
细菌培养在选择性琼脂培养基(ss琼脂)上培养细菌菌落)照片

选择培养基

乳酸杆菌选择性培养基
图片尺寸650x650
pfizer肠球菌选择性培养基(pse琼脂)
图片尺寸700x280
幽门螺杆菌选择培养基
图片尺寸1269x951
琼脂是泌尿生殖器的支原体,解脲支原体和人型支原体培养的选择培养基
图片尺寸500x375
移栽至大田 生根培养基 分化培养基
图片尺寸1080x810
乳酸杆菌选择性培养基原理及实验现象
图片尺寸600x598
常见微生物在常见选择性培养基上的菌落特征(图片已上传)
图片尺寸1600x1200
上海博微 乙酰胺琼脂培养基用于绿脓杆菌的选择性分离培养基250g
图片尺寸800x800
洋葱伯克霍尔德选择性琼脂培养基
图片尺寸842x524
差别性和选择性培养基上的菌落培养.生物技术,健康.图片下载
图片尺寸800x533
i>洋葱博克霍尔德菌 /i> 选择性琼脂平板培养基 (usp 60) 60mm
图片尺寸650x648
细菌培养在选择性琼脂培养基(ss琼脂)上培养细菌菌落)照片
图片尺寸449x300
琼脂培养基在选择性琼脂培养基xlt琼脂xy上培养细菌菌落照片
图片尺寸449x300
实验技术交流细胞培养篇之培养基选择_合成_血清_成份
图片尺寸810x578
选择性培养基
图片尺寸268x268
金黄色葡萄球菌实验室检测的选择培养基
图片尺寸1200x800
在选择性琼脂培养基上进行菌落培养
图片尺寸1200x801
李斯特选择性培养基
图片尺寸600x580
志贺氏菌显色培养基使用说明
图片尺寸1002x1002
在鉴别和选择性培养基上培养细菌菌落照片
图片尺寸449x300